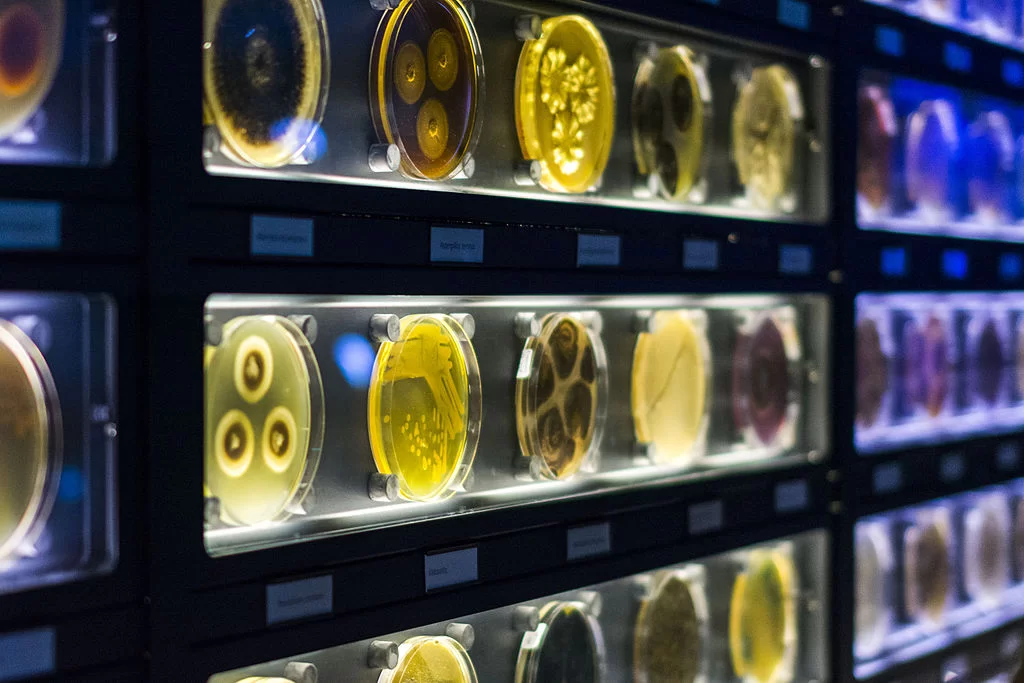
Micropia Micropia

Prowokacyjne stereotypy na temat Amsterdamu często prześladują tych, którzy nigdy nie byli w Holandii. Jednak na całym świecie kraj ten znany jest również jako bastion wartości rodzinnych. Wbrew pogłoskom o «dzielnicy czerwonych latarni», jest to świetne miejsce na rodzinne wakacje. W Holandii jest mnóstwo atrakcji dla dzieci w różnym wieku i teraz się na nich skupimy. Hotel w Holandii można znaleźć pod tym linkiem.
» CZYTAJ TAKŻE – Amsterdam z dziećmi: 10 pomysłów na wakacje
Muzea dla dzieci
Interaktywne Muzeum NEMO Science Museum w Amsterdamie
Niezwykły budynek Muzeum Nemo znajduje się 10 minut spacerem od Dworca Centralnego. Dla dzieci przygotowano cały interaktywny park składający się z pięciu pięter, z których każde poświęcone jest innemu tematowi. W muzeum znajduje się laboratorium, w którym odbywają się eksperymenty chemiczne i przedstawienia z demonstracjami procesów fizycznych. Na ostatnim piętrze znajduje się sekcja poświęcona ludzkiemu ciału. Na trzecim piętrze dzieci mogą zbudować tamę na rzece.
» CZYTAJ TAKŻE – Muzea w Amsterdamie: które z nich warto odwiedzić?
Bilety: wszyscy goście powyżej 4 roku życia – 17,50 €, poniżej 3 roku życia bezpłatnie. Bilety nie są sprzedawane przy wejściu, należy je zarezerwować online. Można też wejść za darmo z kartą I Amsterdam
Godziny otwarcia: od 10:00 do 18:00, poniedziałek jest dniem wolnym
Muzeum Żeglugi (Het Scheepvaartmuseum) w Amsterdamie
To muzeum znajduje się 5 minut spacerem od Muzeum Nemo. Budynek został zbudowany w 1656 roku i był wcześniej używany jako magazyn wojskowy. Jest to cenne muzeum, ponieważ nie można sobie wyobrazić historii Holandii bez morza. Są tu obszary, w których można dowiedzieć się o żegludze w zabawny sposób i odwiedzić paszczę wieloryba. Naprzeciwko zacumowany jest prawdziwy statek z masztami i żaglami.
Bilety: dorośli – 17,50 €, dzieci (4-17 lat) – 8,50 €, poniżej 4 lat wstęp bezpłatny. Kasa biletowa nie przyjmuje gotówki, można płacić tylko kartą lub dokonać rezerwacji online. Wstęp bezpłatny z kartą I Amsterdam
Godziny otwarcia to od 10:00 do 17:00, z wyjątkiem poniedziałków
Muzeum mikroorganizmów «Micropia» w Amsterdamie
Muzeum Micropia to jedyne w swoim rodzaju zoo mikrobów, wirusów i bakterii. Oprócz dużej wystawy, Micropia posiada specjalny skaner, który wyraźnie pokazuje, ile mikroorganizmów znajduje się na twoim ciele. Prowadzone są również badania, które odwiedzający obserwują przez okno. Dowiesz się wielu nowych i nieoczekiwanych rzeczy o tym, co masz teraz na rękach, a także o pocałunkach, które zawsze chętnie rozdajemy.
Muzeum znajduje się obok zoo. Można się tam dostać tramwajem 14 z Dworca Centralnego w kierunku Flevopark. Należy wysiąść na przystanku Artis.
Bilety: od 13 lat 17,50 €, młodsi za darmo. Aby uniknąć mikrobów w kolejce, warto zarezerwować bilet online z wyprzedzeniem
Godziny otwarcia: od 09:00 do 17:00 codziennie bez weekendów
Muzeum kolejnictwa (Het Spoorwegmuseum) w Utrechcie
To muzeum to cała stacja kolejowa! Gromadzi eksponaty od 1927 roku. Obecnie można tu nie tylko pooglądać pociągi, ale także poznać tajniki inżynierii kolejowej, zgłębić umiejętności maszynisty i usiąść w wagonie słynnego na całym świecie Orient Expressu.
Bilety: 17,50 € dla dzieci i dorosłych, poniżej 3 roku życia wstęp jest bezpłatny. Zalecamy wcześniejszą rezerwację biletu tutaj
Godziny otwarcia: od 10:00 do 17:00, poniedziałek jest dniem wolnym
Aby dostać się do muzeum, należy wsiąść w autobus numer 8 i wysiąść na przystanku Maliebaan, a następnie przejść pieszo 600 metrów.
» CZYTAJ TAKŻE – Utrecht: Jak dojechać i gdzie się zatrzymać?
Muzeum samogrających instrumentów muzycznych Speelklok w Utrechcie
Tutaj wszystko śpiewa, nawet zegar ścienny. Muzeum postarało się zgromadzić kolekcję starego sprzętu muzycznego, od najprostszych pozytywek po ogromne instrumenty, które mogą zastąpić całą orkiestrę.
Cena biletu: osoba dorosła 14 €, dzieci (4-12 lat) 7,50 €, poniżej 3 lat bezpłatnie. Pakiet rodzinny (2 dorosłych i 2 dzieci) – 39 €
Adres: Steenweg 6, Utrecht
Muzeum Ciała «Corpus» w Lejdzie
Tutaj można zobaczyć procesy zachodzące w naszym ciele. Pokazują je dokładnie od środka. Dostępne są audioprzewodniki w różnych językach, ale nie w języku polskim.
Cena biletu: 20,95€. Dzieci poniżej 6 roku życia nie mają wstępu
Godziny otwarcia od wtorku do niedzieli od 9:30 do 15:00
Należy wsiąść w autobus 31 i jechać do przystanku Oegstgeest. Spacer na miejsce zajmuje 7 minut.
» CZYTAJ TAKŻE – Lejda: zabytki i atrakcje
Muzeum na świeżym powietrzu (Openluchtmuseum) w Arnhem
To niezwykłe miejsce zgromadziło pod swoim dachem naturalnej wielkości holenderskie domy, młyny, budynki, szpitale i budowle. Kolekcja pochodzi ze wszystkich zakątków kraju. Amsterdam reprezentują przytulne domy z dzielnicy Jordaan. Jest kościół, farmy ze zwierzętami, fabryka sera i masła. Dzięki aktorom to miejsce wydaje się zamieszkane, a my możemy przenieść się w czasie.
Bilety: dorośli – 19,50 €, dzieci (4-12 lat) – 16,50 €, poniżej 4 lat wstęp bezpłatny
Godziny otwarcia: w dni powszednie od 10:00 do 17:00, w weekendy od 10:00 do 18:00
Adres: Hoeferlaan 4, 6816 SG Arnhem
Żeby dojechać do muzeum trzeba się przesiąść. Najpierw jedziemy z dworca głównego w Amsterdamie do Arnhem pociągiem. Następnie autobusem numer 91 do przystanku Moscowa. Następnie można przejść pieszo lub wziąć taksówkę – odległość wynosi 3,6 km.
» CZYTAJ TAKŻE – Jak działa Holandia, część 1: kanały, tamy, młyny
Parki rozrywki
Park rozrywki Efteling
Znajduje się w prowincji Brabancja Północna i przypomina Disneyland. Kompleks obejmuje centrum rozrywki, hotele (wstęp do parku jest bezpłatny dla gości), pole golfowe. Teren jest podzielony na kilka stref tematycznych, więc poruszanie się po nim jest dość łatwe.
Cena biletu: wszyscy goście powyżej 4 lat – 46 €. Parking: 12,50 € za cały dzień
Godziny otwarcia: wrzesień-czerwiec – od 10:00 do 18:00. W święta państwowe – od 10:00 do 19:00. Podczas letnich wakacji szkolnych w Holandii – od 10:00 do 22:00
Adres: Europalaan 1, Kaatsheuvel
» CZYTAJ TAKŻE – Park rozrywek Efteling
Dojazd środkami transportu publicznego: pociągiem do miasta Tilburg, a stamtąd autobusem nr 301 do przystanku Efteling Kaatsheuvel. Podróż zajmie mniej więcej 2,5 godziny. Samochodem – 1 godzinę i 15 minut.
Park rozrywki Walibi Holland
Znajduje się w prowincji Flevoland. Na odwiedzających czeka tu aż czterdzieści różnych atrakcji. Teren podzielony jest na kilka stref tematycznych: Francja, Włochy, Hollywood – Główna Ulica, Jukon, Meksyk, Dziki Zachód, Strefa Prędkości, Las Sherwood i Kraina Walibi. Większość kolejek jest przeznaczona dla dzieci od 140 cm wzrostu. Dla maluchów jest oddzielna część – Walibi Land.
Ceny biletów: dorośli – 31 €, 6-11 lat – 29 €, 3-5 lat – 18 €
Godziny otwarcia to od 10:00 do 17:00 w dni powszednie i do 18:00 w weekendy i święta. Podczas letnich wakacji park jest otwarty od 10:00 do 20:00, a w środy do 23:00
Adres: Spijkweg 30, Biddinghuizen
Należy dojechać do Lelystad (Lelystad Centrum). Następnie wsiąść w autobus numer 148 do Harderwijk, przesiąść się w nr 241 (Walibi Holland) i wysiąść na Biddinghuizen. Całkowity czas podróży to 2 godziny i 40 minut. Samochodem – 1 godzina.
Park miniatur Madurodam w Hadze
Ten park to zbiór wszystkich głównych budynków i budowli Holandii w pomniejszonym rozmiarze. Dla dzieci spacer będzie ekscytujący i interesujący. Wiele eksponatów można dotykać, bawić się nimi i naciskać różnego rodzaju przyciski. Park został zaprojektowany w taki sposób, że w ciągu godziny odwiedzający zapoznają się nie tylko z głównymi zabytkami, ale także poznają historię i kulturę kraju oraz osiągnięcia technologiczne Holendrów.
» CZYTAJ TAKŻE – Co zobaczyć w Hadze w jeden dzień?
Podróż z głównego dworca kolejowego w Hadze zajmuje 16 minut tramwajem #9 i 18 minut tramwajem #22. Należy wysiąść na przystanku Den Haag, Madurodam.
Cena biletu: 17 € dla dorosłych i dzieci, poniżej 2 lat bezpłatnie
Godziny otwarcia: od 09:00 do 20:00 codziennie
Adres: George Maduroplein 1, Haga
Park rozrywki Sprooljes Wonderland w Enkhuizen
Park urządzony jest w bajkowym stylu i spodoba się szczególnie najmłodszym odwiedzającym. Plusem jest jego niewielki rozmiar, szczególnie podczas spacerów z dziećmi. Zwiedzimy tu bajkowy las i prawdziwą farmę, zobaczymy niezwykłe pociągi i samochody, a także pojeździmy na koniach.
Cena biletu: 14,50 €, poniżej 2 roku życia wstęp jest bezpłatny
Godziny otwarcia parku: codziennie od 10:00 do 17:00
Adres: Kooizandweg 9, Enkhuizen
Z głównego dworca kolejowego w Amsterdamie do Enkhuizen można dojechać pociągiem. Czas podróży wynosi 1 godzinę i 30 minut. Ze stacji Enkhuizen do bramy parku idzie się 20 minut.
Park rozrywki i aquapark «Duinrell» w Wassenaar
Znajduje się on pośród piaszczystych wydm i lasu. Na terenie parku znajdziesz atrakcje, tropikalny basen oraz miejsce na kemping. W ofercie są również narty, nurkowanie i wspinaczka.
Cena biletu: od 27,50 € do 32,50 € dla dorosłych i dzieci powyżej 2 roku życia (cena zależy od dnia tygodnia i natężenia ruchu)
Godziny otwarcia: od kwietnia do października od 10:00 do 18:00, basen od 10:00 do 22:00, od listopada do marca park jest zamknięty
Adres: Duinrell 1, Wassenaar. Podróż samochodem zajmuje 30 minut. Należy dojechać pociągiem do głównego dworca kolejowego w Hadze, przesiąść się do autobusu nr 90 i wysiąść na przystanku Wassenaar, Dr. Mansveltkade/Duinrell
Ogrody zoologiczne, farmy i safari
Królewski Ogród Zoologiczny ARTIS w Amsterdamie
Występuje tu ponad dziewięćset gatunków zwierząt. Pracownicy starają się tworzyć jak najbardziej naturalne warunki dla zwierząt. Na terenie ogrodu znajduje się akwarium, planetarium i pawilon «Tropiki».
Cena biletu: 25 € dla dorosłych, 21 € dla dzieci (3-12 lat). Dzieci do lat trzech wchodzą za darmo
Godziny otwarcia: od 09:00 do 18:00
Adres: Plantage Kerklaan 38-40, Amsterdam. Z Dworca Centralnego w Amsterdamie do zoo można dojechać tramwajem numer 14. Przystanek: Artis
Dziecięca farma «De Pijp» w Amsterdamie
W Holandii takie atrakcje są bardzo popularne. Rząd uważa, że w warunkach urbanizacji ważne jest, aby dzieci mogły obcować z zwierzętami i poznawać ich świat. W tym mini-zoo można karmić zwierzęta, głaskać je i bawić się nimi.
Godziny otwarcia: od poniedziałku do piątku od 11:00 do 17:00, w weekendy od 13:00 do 17:00
Wstęp jest bezpłatny
Adres: Lizzy Ansinghstraat 82, Amsterdam. Z Dworca Centralnego w Amsterdamie dojedziesz metrem linii numer 52 na przystanek De Pijp
» CZYTAJ TAKŻE – Wycieczki samochodem do Holandii na własną rękę
Ogród zoologiczny «Diergaarde Blijdorp» w Rotterdamie
Teren ten został prawie całkowicie zniszczony podczas II wojny światowej, podobnie jak sam Rotterdam. Następnie park został odbudowany i prawie podwojono jego rozmiary. Obecnie znajduje się tu oprócz klatek z zwierzętami także akwarium i ogród botaniczny.
Bilety: 23,50 € dla dorosłych, 19 € dla dzieci (3-12 lat). Dzieci do lat trzech wchodzą za darmo
Godziny otwarcia: codziennie od 09:00 do 18:00
Adres: Blijdorplaan 8, Rotterdam. Na miejsce dojedziesz autobusami numer 33 i 40 z Dworca Centralnego w Rotterdamie na przystanek Blijdorpplein
Ogród zoologiczny i park safari «Burgers’ Zoo» w Arnhem
W Arnhem zbudowano prawdziwą afrykańską sawannę i tropikalny las o powierzchni 45 hektarów. Odwiedzający obserwują zwierzęta z specjalnych mostów i punktów widokowych. Na terenie znajduje się rezerwat przyrody, oceanarium oraz mokradła z lamantynami.
Ceny biletów: 25,50 € dla dorosłych, 23 € dla dzieci (4-9 lat), dzieci do lat trzech wchodzą za darmo
Godziny otwarcia: codziennie od 09:00 do 18:00
Adres: Blijdorplaan 8, Rotterdam. Aby dojechać na miejsce, pojedź pociągiem z Dworca Centralnego w Amsterdamie na Dworzec Arnhem, a następnie kontynuuj podróż autobusem numer 3 na przystanek «Zoo Burgers» (Burgers Zoo)
Centrum Życia Morskiego «Sea Life Scheveningen» w Hadze
Na samym brzegu Morza Północnego znajduje się oceanarium z morskimi mieszkańcami. W oceanarium można zobaczyć płaszczki, rekiny, krokodyle i inne interesujące stworzenia podwodnego świata.
Bilety: standardowy – 18,50 €, dzieci (3-11 lat) – 15 €. Dzieci do lat trzech wchodzą za darmo. Bilety z rabatem można zakupić tutaj
Godziny otwarcia: od 10:00 do 18:00
Adres: Strandweg 13, Den Haag. Dojazd z Dworca Centralnego w Hadze (Den Haag Centraal) do parku zajmuje 23 minuty tramwajem numer 1
Park Safari «Beekse Bergen» w Beeks Bergen
Park ten mieści 1250 różnych gatunków, począwszy od małych ssaków, a skończywszy na słoniach, żyrafach i innych dużych mieszkańcach. ego historia sięga 1968 roku, kiedy ludzie poznawali zwierzęta przez okna samochodów. Obecnie teren ten przypomina afrykańską sawannę.
Bilety: 27 € dla dorosłych, 24 € dla dzieci (3-9 lat). Dzieci do lat dwóch wchodzą za darmo. Bilety online na oficjalnej stronie są tańsze
Park czynny jest w godzinach od 10:00 do 17:00
Adres: Beekse Bergen 1, Hilvarenbeek. Podróż z Dworca Centralnego w Tilburgu (Tilburg Centraal) do parku safari zajmuje 15 minut autobusem numer 143, a następnie 35 minut pieszo. Samochodem – 1 godzinę i 15 minut. Auto można wynająć tutaj
Park Ptaków «Avifauna» w Hoorn
Pracownicy starają się na tym terenie odtwarzać naturalne środowiska życia wielu gatunków ptaków. Ptaki nie są zamknięte w klatkach, ale latają obok odwiedzających. Park ma również misję edukacyjną: dowiesz się, ile waży najmniejszy ptak, jaka jest rozpiętość skrzydeł największego, dlaczego flamingi są różowe, a pingwiny nie marzną na lodzie!
Cena biletu: powyżej 3 lat – 18,50 €
Godziny otwarcia: codziennie od 10:00 do 17:00
Adres: Hoorn 65, Alphen aan den Rijn. Park znajduje się w pobliżu Lejdy. Z lotniska Schiphol do parku można dojechać autobusem numer 840, przystanek Alphen a/d Rijn, Ziekenhuis
» CZYTAJ TAKŻE – Jak dostać się z lotniska Schiphol do centrum Amsterdamu?
Kozia farma w Amsterdam Bos
To miejsce jest ukryte w głębi lasu, zacienione drzewami, z dala od miejskiego zgiełku. Dzieci na farmie mogą spotkać kozy, nakarmić je, pogłaskać i pobawić się nimi. Wrażenia i głośny śmiech zostaną z tobą na długo! Na terenie znajduje się kawiarnia, gdzie dorośli mogą wypić herbatę i kawę.
Wstęp jest bezpłatny. Opłata dotyczy tylko samych atrakcji (np. karmienie kóz) i oczywiście kawiarni
Godziny otwarcia: codziennie, z wyjątkiem wtorku, od 10:00 do 17:00
Adres: Nieuwe Meerlaan 4, Amstelveen
Aby dojechać do parku Amsterdam Bos, można wsiąść w tramwaj numer 24 z Dworca Centralnego. Na przystanku Olympisch Stadion należy przesiąść się w autobus #347 lub #357 do Van Nijenrodeweg. Na farmę można dojechać samochodem/taksówką lub rowerem. Wypożyczalnia rowerów znajduje się przy wejściu do parku.
Kocia kawiarnia «Kattencafe Kopjes» w Amsterdamie
W tej kawiarni można wypić herbatę i zjeść deser w towarzystwie wąsatych pyszczków. Podczas gdy dorośli rozmawiają, dzieci mogą się pobawić z przyjaznymi kociętami. Wstęp do kawiarni kosztuje 4 €.
Godziny otwarcia: od środy do soboty od 10:00 do 19:00
Adres: Marco Polostraat 211, Amsterdam. Na miejsce można dojechać autobusem numer 18 na przystanek Marco Polostraat
Ogromną zaletą holenderskich muzeów i parków jest to, że eksponaty można dotykać, naciskać wszystkie przyciski, ciągnąć za dźwignie i zadawać wszystkie pytania, których dzieci zawsze mają tak wiele! Spędzisz tu wspaniały czas z rodziną i pokażesz swoim dzieciom wiele niesamowitych rzeczy!

Shinnosuke Ando / unsplash.com
Andrea García / Unsplash
User:Thbz / commons.wikimedia.org / CC BY-SA 3.0
Marcelo Campi / Flickr / CC BY SA 2.0
dimitrisvetsikas1969 / Pixabay
Dodaj komentarz
Chcesz się przyłączyć do dyskusji?Feel free to contribute!